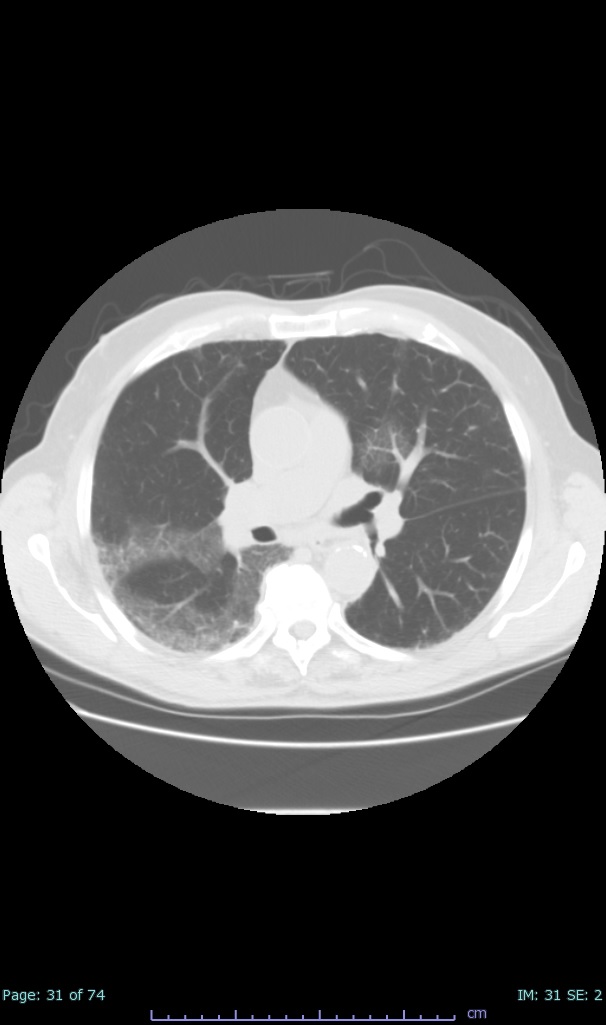
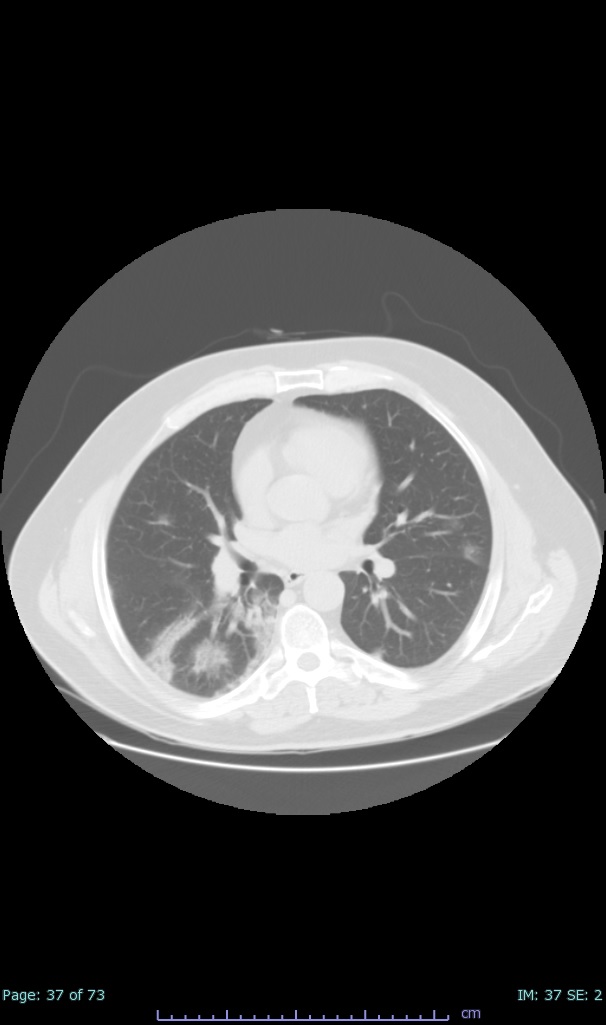

- 100% subpleural involvement, 33% + centrolobular involvement
- 40% even apical/basilar, 27% basilar dom, 5% mid dom. 1/17
- 66% had some + CXR finding I could correlate to a CT finding
- 66% had documented exposure, rest I couldn't find either way
I'll list age decade and + exposure documented #covid19 #coronavirus #radiology #FOAMed #radres 2/17